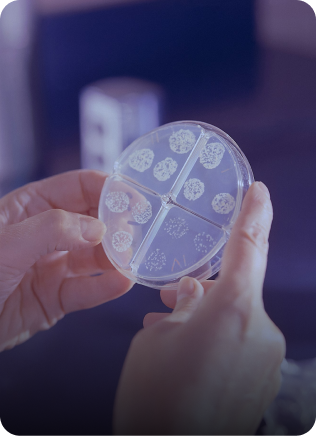
Chandigarh Diagnostic Laboratories

Error FREE
Pathological Tests
Haematology, Clinic Chemistry, Immunoassay, Elisa, Microbiology, Cancer Markers, Bone Marrow, Histopathology, FNAC
HEALTH PACKAGES
ATTRACTIVE PACKAGES
LOCATE US
CENTRALLY LOCATED
REPORTS VERIFIED
ON CLICK
HOME COLLECTION
AT YOUR DOORSTEPS
Your Health Packages
At Your Health Packages, we provide tailored wellness solutions designed to meet your unique health needs. With comprehensive care options, expert guidance, and affordability at the core, we empower you to take charge of your well-being. Your journey to a healthier life starts here.
Diabetic Health Package
Including: 9 Test
Fasting Required: 10-12 hours
Report Time: Same Day
₹2,499 ₹1,799
LIVER & KIDNEY
Including: 9 Test
Fasting Required: 10-12 hours
Report Time: Same Day
₹1,999 ₹1,445
C-REACTIVE PROTEIN; CRP
Including: 9 Test
Fasting Required: 10-12 hours
Report Time: Same Day
₹999
DENGUE FEVER NS1 ANTIGEN, EIA
Including: 9 Test
Fasting Required: 10-12 hours
Report Time: Same Day
₹2,999 ₹2,145
VITAMIN D 25 - HYDROXY
Including: 9 Test
Fasting Required: 10-12 hours
Report Time: Same Day
₹4,499 ₹3,599
ESR; ERYTHROCYTE SEDIMENT...
Including: 9 Test
Fasting Required: 10-12 hours
Report Time: Same Day
₹6,599 ₹4,499
VITAMIN B12; CYANOCOBALAMIN
Including: 9 Test
Fasting Required: 10-12 hours
Report Time: Same Day
₹3,999
Test By Organs
Neurology
Liver
Bacteria Cell Microbe
Gland Male Orchis
Abdomen
Backbone
Gland Insulin
Bladder Kidneys
Bone Femur Joint
Blood Cell
Lungs
Abdomen Digestion Gaster
Bile Cholescyst Gallbladder
Blood Coronary
Excretion Organ
Bundle Fibre Muscle
Bowel Digestion
Bowel Colon Digestion
Gland Larynx
Male Organ
Abdomen Lymph
Female Organ Reproduction
Dermis Epidermis
Facilities at CDL
CDL's Diagnostic facilities are established using state-of-the-art equipment and gold standard operating procedures. We believe in having the best minds working with and allow our Human Resources to work to the best of their abilities.

Fully Automated
Best in Class Infrastructure
100% Calibration and Results
Equipped with Biochemistry & Immunology Equipments

Quality Compliance
World Class Services all Under One Roof
© 2024 Chandigarh Diagnostic Laboratories. All Rights Reserved.